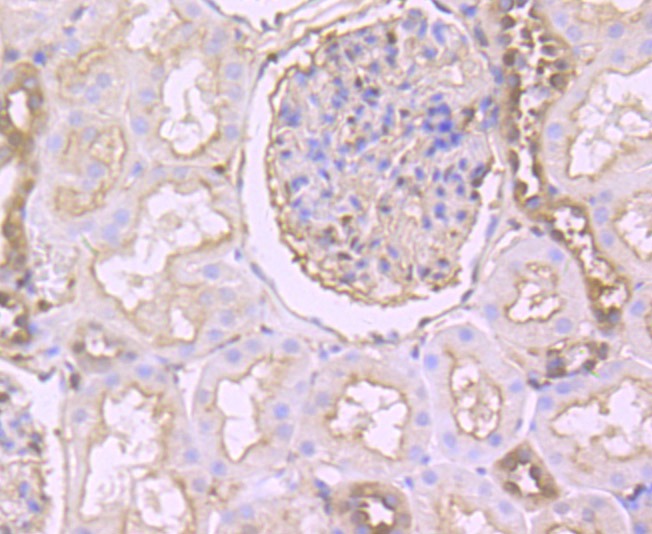

购物车
 您的购物车当前为空
您的购物车当前为空
Anti-GSN Antibody (3E486) 是一种 Rabbit 抗体,靶向 GSN。Anti-GSN Antibody (3E486) 可用于 FCM,ICC,IF,IHC,WB。
Anti-GSN Antibody (3E486) 是一种 Rabbit 抗体,靶向 GSN。Anti-GSN Antibody (3E486) 可用于 FCM,ICC,IF,IHC,WB。
| 规格 | 价格 | 库存 | 数量 |
|---|---|---|---|
| 50 μL | ¥ 1,485 | 5日内发货 | |
| 100 μL | ¥ 2,480 | 5日内发货 |
TargetMol的所有产品仅用作科学研究或药证申报,不能被用于人体,我们不向个人提供产品和服务。请您遵守承诺用途,不得违反法律法规规定用于任何其他用途。
| 产品描述 | Anti-GSN Antibody (3E486) is a Rabbit antibody targeting GSN. Anti-GSN Antibody (3E486) can be used in FCM,ICC,IF,IHC,WB. |
| Ig Type | IgG |
| 克隆号 | 3E486 |
| 反应种属 | Human,Mouse |
| 验证活性 | 1. Western blot analysis of Gelsolin on different lysates using anti-Gelsolin antibody at 1/500 dilution. Positive control: Lane 1: Mouse thymus, Lane 2: Mouse lung, Lane 3: THP-1, Lane 4: HepG2. 2. Immunohistochemical analysis of paraffin-embedded human kidney tissue using anti-Gelsolin antibody. Counter stained with hematoxylin. 3. Immunohistochemical analysis of paraffin-embedded mouse lung tissue using anti-Gelsolin antibody. Counter stained with hematoxylin. 4. Immunohistochemical analysis of paraffin-embedded human spleen tissue using anti-Gelsolin antibody. Counter stained with hematoxylin. 5. ICC staining Gelsolin in NIH-3T3 cells (green). The nuclear counter stain is DAPI (blue). Cells were fixed in paraformaldehyde, permeabilised with 0.25% Triton X100/PBS. 6. ICC staining Gelsolin in SiHa cells (green). The nuclear counter stain is DAPI (blue). Cells were fixed in paraformaldehyde, permeabilised with 0.25% Triton X100/PBS. 7. Flow cytometric analysis of THP-1 cells with Gelsolin antibody at 1/100 dilution (red) compared with an unlabelled control (cells without incubation with primary antibody; black). Alexa Fluor 488-conjugated goat anti-rabbit IgG was used as the secondary antibody. |
| 应用 | FCMICCIFIHCWB |
| 推荐剂量 | WB: 1:500-2000; IHC: 1:50-200; ICC: 1:50-200; FCM: 1:50-100 |
| 抗体种类 | Monoclonal |
| 宿主来源 | Rabbit |
| 构建方式 | Recombinant Antibody |
| 纯化方式 | ProA affinity purified |
| 性状 | Liquid |
| 缓冲液 | 1*TBS (pH7.4), 1%BSA, 40%Glycerol. Preservative: 0.05% Sodium Azide. |
| 研究背景 | Gelsolin (also known as brevin, Actin-depolymerizing factor or ADF), a protein of leukocytes, platelets and other cells, severs Actin filaments in the presence of submicromolar calcium, thereby isolating cytoplasmic Actin gels. A calcium-independent mechanism reverses the process. A Gelsolin variant with 23 more amino-terminal amino acids is a plasma component probably involved in the clearance of Actin, the most abundant human protein, from the circulation. It has been suggested that a single gene encodes both cell and plasma gelsolins. Gelsolin may be unique in that it is made for both secretion and intracytoplasmic location. Amino acid homology was identified between Gelsolin and the amyloid of the Finnish variety of amyloidosis. The amyloid in this disorder is antigenically and structurally related to Gelsolin. Gelsolin is the principal intracellular and extracellular Actin-severing protein. Gelsolin and Gc protein together constitute the extracellular Actin-scavenger system which prevents the toxic effects of Actin release into the extracellular space under circumstances of cell necrosis. |
| 偶联 | Unconjugated |
| 免疫原 | Recombinant Protein |
| Uniprot ID |
| 分子量 | Theoretical: 86 kDa. |
| 储存方式 | Store at -20°C or -80°C for 12 months. Avoid repeated freeze-thaw cycles. |
| 运输方式 | Shipping with blue ice. |